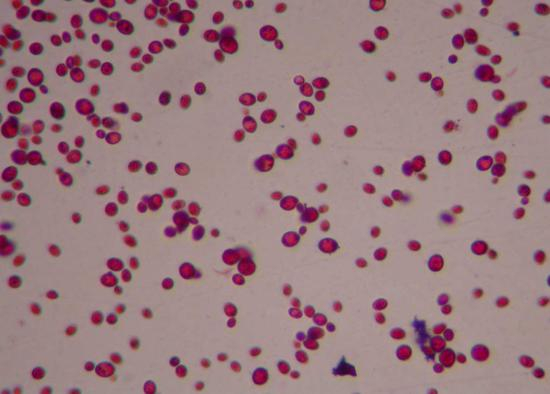

来源:Quanta Magazine
撰写:维维安·卡利尔(Viviane Callier)
翻译:叶子
当克里斯蒂安·卡内斯特罗十几年前刚开始研究有大脑和脊柱的动物的进化史时,他将一种名叫住囊虫(Oikopleura)的海鞘生物选为了自己的研究对象。和所有海鞘动物一样,它长有一个迷你大脑和一条神经索,但与其它海鞘生物不同的是,住囊虫在长大成熟的过程中不会经历变态发育,这也许是因为住囊虫比其它海鞘生物保留了更多远古时期的简单特征,还能帮助科学家追溯其进化的起源。
“但这项研究使我备受打击。”卡内斯特罗表示,他的研究团队一直没能找到住囊虫基因组中本应该有的一部分基因。之所以说“应该有”,是因为绝大部分动物体内都保留有这些基因。与维A酸合成、改造及降解相关的基因更是一个也没有,与维A酸受体相关的基因也是如此,然而,维A酸信号对大脑、神经索及其它关键特征的形成是至关重要的。不仅如此,住囊虫还缺少一个似乎对激发心脏组织形成必不可缺的基因。

生物在进化过程中经常失去看似重要的基因。但它们借助新颖的解决方法,不仅能生存下去,还能繁荣兴旺。
“如果让你在脑海中想象出一辆车,这辆车肯定有轮子,对吧?那如果我让你去找一辆没有轮子的车呢?”卡内斯特罗反问道,“我们原以为某些东西是不可或缺的,然而它们并不在那儿,尽管它们创造的结构就在那里。这会令你对某些基因的必要性产生反思。”
今年年初,《自然生态与进化》上发表了两篇令人震惊的分析,指出了基因的不必要性,以及进化解决基因缺失问题的创造力。西班牙和英国的研究人员分析了成百上千个动物基因组,由此发现,在生命之树上基因丢失现象之普遍能够达到令人咋舌的程度。
他们的研究结果显示,由于在地球生命史早期,基因复制发生了前所未有的激增,因此就连早期动物也拥有较为复杂的基因组。在此之后,随着各动物世系逐渐演化成为不同的门、形成了区别显著的身体结构,许多基因开始消失,并且自此之后,基因丢失一直是影响进化的主要因素之一。事实上,基因的丢失似乎帮助了许多种类的生物与它们的祖先剥离开来,并成功解决了全新的环境挑战。

就像其它海鞘动物一样,住囊虫也长有一个迷你大脑和一条神经索。但它体内少了很多科学家原以为不可或缺的基因,包括与大脑和神经索结构相关的基因,以及其它动物体内普遍存在的基因。
直到不久之前,进化过程中的基因丢失一直是个难以研究的课题,因为“如果你没看到某样东西,可能是因为它不在那里,也可能是因为你没能找到它。”科学家过去认为,基因丢失也许在共生或寄生物种之中最为常见,因为它们可以将许多必需功能“外包”给共生伴侣或宿主,从而实现自身的简化。
不过,有了更多高质量的基因组可供研究,研究人员如今可以对整个动物界的基因丢失现象展开分析,他们发现,该现象其实并不仅限于简单动物或寄生动物,在动物的进化过程中的一些阶段,基因的丢失与形态的简化并不是同步出现的。

科学家如今意识到,基因丢失在整个动物界对进化都具有重要意义,这无疑打开了新研究的大门。在研究基因的作用时,遗传学家可以培育出拥有“基因敲除”变异的实验室小鼠,借此观察动物是否会、以及如何应对基因的丢失。科学家已经发现,大自然其实一直在开展大范围的基因敲除实验,并且实验对象不仅是住囊虫这样的简单生物,还包括各种各样的复杂生物。这将帮助科学家更充分地了解进化与生物发育对彼此的影响。这就是所谓“进化发育学”的研究重点。
不用就扔
进化过程中丢失基因听上去似乎是件很可怕的事情,毕竟由基因转达的种种性状对生命健康至关重要。假如某人缺少一个必不可缺的基因,就可能死亡、或者无法健康成长,自然选择会将他们从人类群体中“清扫”出去。不过实际进化过程中丢失的大部分基因也许都是中性的,不会对生物体的健康造成影响。

这是因为,进化中的基因丢失往往发生在环境或生物行为发生变化之后。这些变化会使得某个基因的必要性减弱。例如,假如某种关键营养物质或维生素的供应突然变得充足了许多,这些物质的生物合成通路或许就会变得可有可无,再加上变异或其它遗传事故,这些通路也许就会彻底消失。基因丢失也可能出现在偶然发生的基因复制之后,如果多余的基因发生了退化,这个基因就会彻底丢失,因为自然选择不会再继续保留它了。
这种“不用就扔”的策略在植物界广泛存在。因为许多植物品种在经历了全基因组复制后,都发生了基因丢失的现象。有时重复的基因会在植物基因组中保留数百万年之久、才会被清除出去。至于原因,科学家仍在调查之中。
在近期一项研究中,中国和美国加州的研究人员考察了全球各地多种拟南芥植物的基因形式,结果发现,在负责蛋白质编码的基因中,有66%都有缺损版本,即功能不全的基因变体。令人惊讶的是,在这些功能不全的基因中,有1%的基因竟然经历了进化正选择。也就是说,拥有这些缺损基因的植物反而生长得比拥有完整基因的植物更加茁壮旺盛。这些结果进一步验证了华盛顿大学遗传学家梅纳德·奥尔森(Maynard Olson)1999年提出的惊人理论,即“少即是多”:有时候,缺少一个基因对植物而言反而更适合。

海豚等鲸目动物体内少了几十个基因。由于失去了特定基因,它们长出了更厚、且没有毛发的皮肤,以便适应水生环境。
这种现象在鲸目动物(包括鲸鱼和海豚等水生哺乳动物)身上体现得淋漓尽致。这些动物与其它哺乳动物相比,缺少了85个蛋白质编码基因,其中许多似乎是中性的,但有些似乎与针对潜水做出的适应有关,例如在下潜过程中、血管需要收缩。在缺失的基因中,一个名叫KLK8的基因最有意思,因为它既与皮肤中汗腺的发育有关、又与大脑中海马体的发育有关。而鲸目动物在从陆地回到大海的过程中失去了这个基因,使得它们进化出了更厚的表皮、并且不再生长毛发(毛发不适合水下环境,因为会在水中造成阻力,并且无法像在陆地上一样,起到身体的保温作用)。
可以预见的缺失
为弄清基因丢失发生的重复性和可预测性,科学家研究了食肉和食草哺乳动物中的趋同性基因丢失现象。在丢失的基因中,许多都与动物不再需要的某种功能有关,但至少有一种基因的丢失属于适应性丢失。
有一种名叫PNLIPRP1的蛋白质,它可以对负责消化脂肪的酶产生抑制。许多品种的食草动物都各自独立地失去了负责该蛋白质编码的基因,但特定的食肉动物则保留了该基因。在实验中,如果研究人员“敲除”了小鼠基因组中的这个基因(小鼠属于杂食动物),小鼠就会变得超重,因为从食物中摄取的热量过多。也许食草动物需要从低脂肪食物中尽可能获取更多的热量,因此就没有理由保留PNLIPRP了。

粒毛盘菌属菌保留了一些多细胞真菌才有的基因和特征。单细胞酵母则已经失去了这些基因。
在相似环境中生存的酵母菌也会发生类似的趋同性基因丢失现象。研究人员对一类名叫粒毛盘菌属的神秘微生物产生了兴趣,尽管它们与酵母菌属于同一类别,却拥有多细胞真菌的全部特征。在对粒毛盘菌属下的一个品种开展的基因组测序中,结果发现了数百个粒毛盘菌属与其它多细胞真菌共有的古老基因,但这些基因在芽殖酵母菌(常用于酿酒和烘焙)和裂殖酵母菌(在中非用于酿造香蕉啤酒)中均已丢失。
这些发现说明,这些酵母的祖先都是多细胞微生物,但后来各自演化出了单细胞的生存方式。由于它们丢失的基因中有许多都与有氧代谢反应有关,芽殖酵母和裂殖酵母为了在厌氧环境下生存,也许便出于功能考虑、分别丢弃了这些基因。这种趋同性的基因变化也许是应对酵母菌作为单细胞和“兼性厌氧”的生存方式的最佳策略。这一点很有意思,因为它说明,进化也许比我们之前认为的更具有可预测性和可确定性。
随后一项更全面的酵母菌基因组分析显示,基因丢失现象在整个酵母门中都十分普遍,研究结果显示,还原性进化是进化分化的一种主要模式。
当然,通过丢弃特定基因实现进化的风险在于,就算某个基因在特定环境条件下变得可有可无,也许在数百万年之后,它又会重新变得必要起来。到那时又该怎么办呢?事实上,科学家发现,酵母有时可以找回自己丢失的基因。

研究人员正在观察一种失去了酒精发酵酶的酵母。当酵母菌通过基因水平转移、从细菌身上获取这些基因后,发酵酒精的能力竟然失而复得了。酵母之前其实失去了很多与各类代谢通路相关的基因,后来由从各种细菌身上、重新获得了这些基因。
旧题新解
酵母的代谢复杂程度并不算罕见。海豚和鲸鱼、果蝠、以及大象这三类生物都长有相对较大的大脑,并且都失去了进行生酮作用的必需基因HMGCS2。科学家认为,要想为体积大、耗能多的大脑提供支持,这一代谢过程是必不可少的。脑细胞会消耗葡萄糖,但当缺少葡萄糖时,它们就会将脂肪酸转化为酮体、从而为自己提供能量。HGMCS2正是负责将脂肪酸转化为酮体的酶,在断食期间对身体尤为重要。

多年来,巴塞罗那大学遗传学家、微生物学家和统计学家卡内斯特罗一直认为,基因丢失是一种适应性的进化手段。
体内不含这种酶的动物往往挨不了饿。缺少这种基因的果蝠仅仅饿上24小时便会死亡。但鲸目动物和大象坚持的时间均比果蝠长得多。这说明,它们一定是找到了其它什么方法,在饥饿时给大脑提供能量。
事实上,进化记录显示,早在大象和鲸目动物分别进化出较大的大脑之前,HGMCS2就已经丢失了。在哺乳动物的进化过程中,较大的大脑至少有两次是在缺少生酮过程的情况下进化出来的,这说明能量代谢也许比我们之前认为的更为灵活。

至于大象和鲸目动物究竟是如何在缺少生酮过程的情况下为大脑提供能量的,科学家至今仍不清楚。但它们似乎进化出了各式各样的方法,解决这一生理性挑战。“如果没有观察到它们缺少这个关键基因,我们根本意识不到这些动物属于例外情况。”
这些例子非常有意思。这些新颖的解决方式在刚刚出现时,也许并不是这些动物的最优选择,但随着时间的流逝,它们却逐渐取代了原先的大脑供能方式。
为了解决代谢或发育方面的问题,进化通过精简关键基因,提出了各式各样的解决方案。这不仅能帮助我们进一步理解生物学,还能为我们提供医学上的启发。

人类体内如果缺乏某些基因,就会导致疾病。希勒特意对体内缺少这些基因的动物展开了考察。有时,这些基因的缺失并不会在其它哺乳动物身上引发病症。例如当对应TBX22转录因子的基因在人体内无法正常发挥作用时,就会导致唇腭裂。但豚鼠、狗和金毛鼹都没有这个基因。如果能弄清它们为何不会发生唇腭裂,也许能为相关生物医学研究指出一条明路。
这种研究方法无疑是反其道而行之。一般来说,研究人员在研究致病基因变异时,都会将这些变异基因引入小鼠或其它实验生物体内、使它们患病。但通过研究进化过程中被“敲除”的基因,也许能帮助我们弄清“如何在缺少某种基因的情况下不患病。”
基因丢失现象在生命之树上如此普遍,使人们对进化发育生物学的一个经典主题展开了逆向思考。上世纪70和80年代,人们震惊地发现,苍蝇和人类竟然拥有相同的基因。如果将苍蝇体内的Pax6基因换成人类体内的同一种基因,苍蝇仍然能长出眼睛。而如今我们发现,有时尽管生理结构相同,但负责该结构的基因却可以千差万别。结构明明是相同的,却对应着那么多不同的基因,这怎么可能呢?这就是进化发育学的“逆悖论”。


